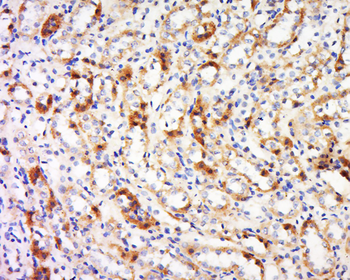
Transglutaminase 6 Rabbit Polyclonal Antibody

You have no items in your shopping cart.
- REEP1 Rabbit Polyclonal Antibody [orb158273]
WB
Mouse
Bovine, Canine, Equine, Gallus, Human, Porcine, Rabbit, Rat, Sheep
Rabbit
Polyclonal
Unconjugated
50 μl, 100 μl, 200 μl - Senataxin Rabbit Polyclonal Antibody [orb158366]
IF, IHC-Fr, IHC-P
Mouse
Bovine, Canine, Equine, Human, Rat, Sheep
Rabbit
Polyclonal
Unconjugated
50 μl, 100 μl, 200 μl - SRSF7 Rabbit Polyclonal Antibody [orb158373]
IF, IHC-Fr, IHC-P
Rat
Bovine, Gallus, Human, Mouse, Zebrafish
Rabbit
Polyclonal
Unconjugated
50 μl, 100 μl, 200 μl - SCGN Rabbit Polyclonal Antibody [orb158344]
IF, IHC-Fr, IHC-P
Mouse
Bovine, Canine, Equine, Human, Porcine, Rat, Sheep
Rabbit
Polyclonal
Unconjugated
50 μl, 100 μl, 200 μl - AKR7A2 Rabbit Polyclonal Antibody [orb158496]
WB
Mouse
Human, Rat
Rabbit
Polyclonal
Unconjugated
50 μl, 100 μl, 200 μl - Phospho-Tau (Ser733) Rabbit Polyclonal Antibody [orb158568]
WB
Mouse, Rat
Bovine, Canine, Equine, Gallus, Human
Rabbit
Polyclonal
Unconjugated
100 μl, 50 μl, 200 μl - Phospho-Tau (Ser739) Rabbit Polyclonal Antibody [orb158569]
IF, IHC-Fr, IHC-P, WB
Mouse, Rat
Bovine, Canine, Human, Rabbit
Rabbit
Polyclonal
Unconjugated
100 μl, 50 μl, 200 μl - Phospho-Tau (Thr529) Rabbit Polyclonal Antibody [orb158571]
WB
Mouse
Bovine, Canine, Equine, Human, Rabbit, Rat
Rabbit
Polyclonal
Unconjugated
50 μl, 200 μl, 100 μl - Transglutaminase 6 Rabbit Polyclonal Antibody [orb158594]
IF, IHC-Fr, IHC-P
Rat
Bovine, Canine, Equine, Human, Mouse, Sheep
Rabbit
Polyclonal
Unconjugated
50 μl, 100 μl, 200 μl - UBE3A Rabbit Polyclonal Antibody [orb158676]
IF, IHC-Fr, IHC-P
Human
Bovine, Canine, Equine, Mouse, Porcine, Rabbit, Rat, Sheep
Rabbit
Polyclonal
Unconjugated
50 μl, 100 μl, 200 μl